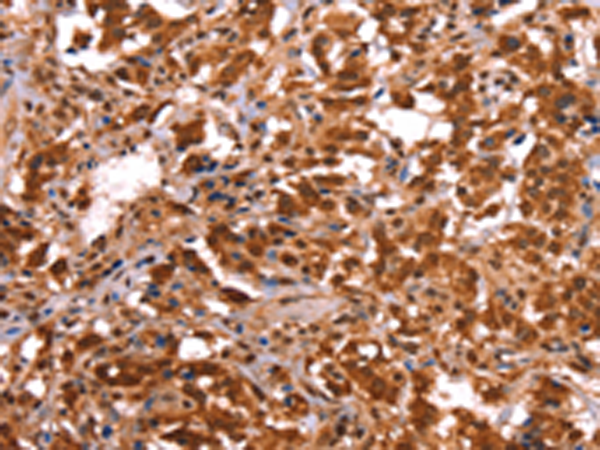

|
Background: |
This gene encodes a protein with similarity to the estrogen receptor. Its function is unknown; however, a similar protein in mouse plays an essential role in placental development. |
|
Applications: |
ELISA, IHC |
|
Name of antibody: |
ESRRB |
|
Immunogen: |
Synthetic peptide of human ESRRB |
|
Full name: |
estrogen-related receptor beta |
|
Synonyms: |
ERR2; ERRb; ESRL2; NR3B2; DFNB35 |
|
SwissProt: |
O95718 |
|
ELISA Recommended dilution: |
2000-5000 |
|
IHC positive control: |
Human thyroid cancer and Human ovarian cancer |
|
IHC Recommend dilution: |
50-200 |
購(gòu)物車
購(gòu)物車 幫助
幫助
 021-54845833/15800441009
021-54845833/15800441009
